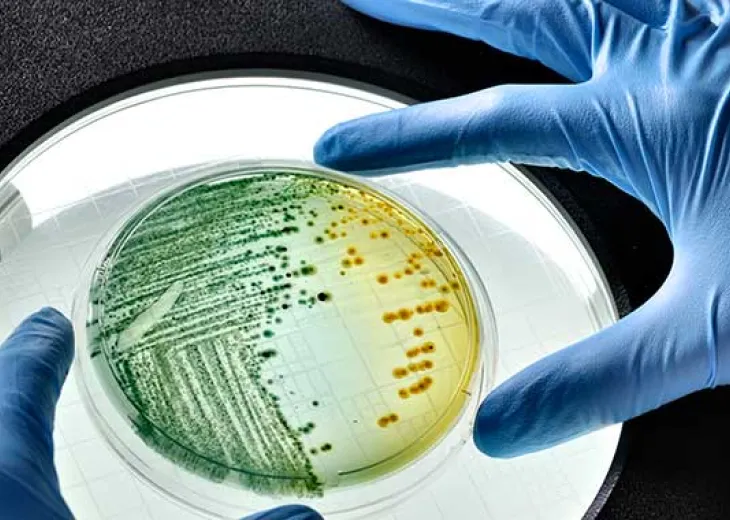
GLS Antimicrobial

Repellant & Antimicrobial Additives
Add an extra level of protection to plastic products with Avient’s portfolio of repellant and antimicrobial additives. Protect wires and cables from rats and termites, help fight against malaria with mosquito repelling concentrates for mosquito nets, and reduce microbe growth on plastic surfaces. Learn more below about the products in this range.

Cesa™ Aversive Technology
Protect your wire and cable or other products from rats, or termites with these low-concern additives.
More
Cesa™ Fiber Antimosquito Additives
Cesa™ Fiber Antimosquito Additives enable the production of especially durable, efficient mosquito nets that keep their functionality for more than five years and 20 washings as per WHO recommendations.
More
Cesa™ WithStand™ Antimicrobial Additives
Cesa™ WithStand™ Antimicrobial Additives counteract bacteria, fungi and microbes to enhance the performance of plastic products and devices.
More- Screen Printing Inks
- Advanced Composites
- Advanced Composites Explained
- Composite Ballistic Protection
- Continuous Fiber Composite Panels
- CRTM™ Panels
- Hammerhead™ FR Flame Retardant Composite Panels
- Hammerhead™ Marine Composite Panels
- Polystrand™ Thermoplastic Composite Panels
- Continuous Fiber Composite Tape, Laminates and Barstock
- Gordon Composites™ Thermoset Laminates & Barstock
- Gordon Glass™ Archery Bow Limbs
- Polystrand™ Continuous Fiber Tapes & Laminates
- Pultrusion and Continuous Filament Winding Technology
- Advanced Composite Springs
- Composite Heat Release Technology
- Glasforms™ Continuous Filament Wound Tubes & Poles
- Glasforms™ Pultruded Rods, Tubes & Custom Profiles
- GridCore™ Composite Utility Poles
- Short & Long Fiber Formulations
- Engineered Polymer Formulations
- Chemical & Corrosion Resistant Formulations
- Complēt™ PKE Formulations
- Long Fiber Technology
- Trilliant™ HC Healthcare Thermoplastics
- Edgetek™ PKE Polyketone Formulations
- Conductive, Signal & Radiation Shielding Formulations
- Colorant Chromatics™ Conductive Formulations
- Edgetek™ Formulations for 5G
- PREPERM™ Low Loss Dielectric Thermoplastics
- Stat-Tech™ Static Dissipative & Electrically Conductive Formulations
- Surround™ EMI/RFI Shielding Formulations
- Therma-Tech™ Thermally Conductive Formulations
- Trilliant™ XR Lead Replacement Thermoplastics
- Flame Retardant Formulations
- Bergamid™ FR Non-Halogen Flame Retardant Formulations
- ECCOH™ Low Smoke and Fume Non-Halogen Formulations
- ECCOH™ XL Cross-Linkable Solutions
- FireCon™ CPE Insulation Jacketing Formulations
- Maxxam™ FR Flame Retardant Formulations and Maxxam™ NHFR Non-Halogen Flame Retardant Formulations
- Syncure™ XLPE Cross-linkable Polyethylene Formulations
- General Engineered Formulations
- Artisan™ Pre-Colored Thermoplastics for Premium Finishes
- Maxxam™ Foamable Formulations
- Bergamid™ / Edgetek™ Solutions for Laser Welding
- Bergadur™ Polyester Formulations
- Custom Pre-Colored Specialty Engineered Formulations
- Edgetek™ 3D/LDS Solutions
- Edgetek™ Engineered Polymer Formulations
- Gravi-Tech™ Density Modified Formulations
- LubriOne™ Internally Lubricated Formulations
- Maxxam™ Polyolefin Formulations
- Nymax™ / Bergamid™ Polyamide Formulations
- High-Temperature Polymer Formulations
- Colorant Chromatics™ Cross-Linked Formulations
- Colorant Chromatics™ Reinforced Formulations
- Colorant Chromatics™ X-Ray Opaque Formulations
- COMPTEK™ High-Temperature Polymer Concentrates
- Edgetek™ PK PEEK Formulations
- Structural + Fiber Reinforced Formulations
- Sustainable Formulations
- ECCOH™ Low Smoke and Fume Non-Halogen Formulations
- ECCOH™ XL Cross-Linkable Solutions
- Edgetek™ LD
- Edgetek™ REC PC Recycled Polycarbonate Solutions
- Gravi-Tech™ BIO Bio-Based Formulations
- Gravi-Tech™ Lead Replacement Formulations
- Gravi-Tech™ REC Recycled Formulations
- Long Fiber Technology
- Maxxam™ BIO Bio-Based Polyolefin Formulations
- Maxxam™ REC Recycled Polyolefin Formulations
- Nymax™ BIO Bio-based Polyamide Solutions
- Nymax™ REC Recycled Nylon Formulations
- Long Fiber Technology
- Long Fiber Technologies
- Complēt™ Long Fiber Reinforced Structural Thermoplastics
- Surround™ EMI/RFI Shielding Formulations
- Complēt™ Moisture Resistant Nylons
- Complēt™ MT Long Fiber Composites
- Complēt™ PKE Formulations
- Complēt™ REC Formulations
- OnForce™ Long Glass Fiber Reinforced Polypropylene Composites
- Long Fiber Solutions
- Printing and Marking Inks
- Colorant Chromatics™ Inks
- Colorant Chromatics™ LND Coatings
- Colorant Chromatics™ Low Temperature Inks
- Colorant Chromatics™ Marking Inks
- Polymer Additives
- Additive Dispersions
- Aquamix™ Additive Formulations
- Silcosperse™ EC Electrically Conductive Additive Dispersions
- Silcosperse™ LM Laser Marking Dispersions
- Silcosperse™ TC Thermally Conductive Dispersions
- Silcosperse™ Additive Dispersions
- Silcocat™ Peroxide Dispersions
- Anti-Counterfeiting
- Antioxidant Additives
- Barrier and Scavenger Additives
- ColorMatrix™ AAnchor™ Acetaldehyde Scavenger
- ColorMatrix™ AAzure™ Acetaldehyde Control Technology for PET
- ColorMatrix™ Amosorb™ 4020L
- ColorMatrix™ Amosorb™ Oxyloop-1
- ColorMatrix™ Amosorb™ 4020R rPET Booster
- ColorMatrix™ Amosorb™ Low-Haze
- ColorMatrix™ Amosorb™ Oxygen Scavenger for PET
- ColorMatrix™ Amosorb™ SolO2 Co2 Barrier and Oxygen Scavenger for PET
- ColorMatrix™ Capture™ Oxygen Scavenger
- ColorMatrix™ Triple A™ Acetaldehyde Scavenger for PET
- Biopolymer Colorants and Additives
- Cesa™ Bio Additives
- Mevopur™ Healthcare Bio-based Polymer Solutions
- OnColor™ Bio Colorants
- OnColor™ Naturals Colorants
- Chain Extender Additives
- Clarifier Additives
- Colorants and Additives for Wire & Cable
- Cesa™ Aversive Technology
- Cesa™ Dry Silane Additives For Wire & Cable
- Cesa™ Flame Retardant Additives
- Cesa™ Laser Additives
- Colorant Chromatics™ Dispersed Pigments for PTFE
- Colorant Chromatics™ ECTFE / ETFE Colorants
- Colorant Chromatics™ FEP Colorants
- Colorant Chromatics™ Inks
- Colorant Chromatics™ LND Coatings
- Colorant Chromatics™ Low Temperature Inks
- Colorant Chromatics™ Marking Inks for PTFE
- Colorant Chromatics™ PFA/MFA Colorants
- Colorant Chromatics™ PVdF Colorants
- Colorant Chromatics™ Reinforced Formulations
- OnColor™ Colorants for Wire & Cable
- Smartbatch™ Combination Colorants and Additives
- Colorant Chromatics™ Conductive Formulations
- Colorant Chromatics™ PEEK and PEI-Siloxane (SILTEM™ resin) Colorants & Pre-colored Solutions
- Maxxam™ Foamable Formulations
- Corrosion Resistant Additives
- Electrical Performance Additives
- Cesa™ Conductive Additives
- Cesa™ Flame Retardant Additives
- Cesa™ Stat Antistatic Additives
- OnColor™ UL 94 Colorants for Electrical and Electronic Applications
- Fiber Additives
- Cesa™ Antimosquito Masterbatch
- Cesa™ Fiber Additives
- Cesa™ Fiber Antimosquito Additives
- Cesa™ Fiber Tracer Concentrates
- MagIQ™ Liquid Fiber Additives and Colorants
- MagIQ™ Nonwoven Electret Additives
- Flame Retardants and Compliant Solutions
- Cesa™ Flame Retardant Additives
- OnColor™ UL 94 Colorants for Electrical and Electronic Applications
- Silcosperse™ Additive Dispersions
- Foaming Agents
- Fragrance Enhancement Additives
- Healthcare Additives
- Mevopur™ Healthcare Bio-based Polymer Solutions
- Mevopur™ Healthcare Functional Additives
- Mevopur™ LQ Liquid Color & Additives for Healthcare
- Laser Marking Additives
- Cesa™ Laser Marking Additives
- Silcosperse™ LM Laser Marking
- Colorant Chromatics™ UV Laser Marking Technology
- Mevopur™ Healthcare Functional Additives
- Processing Enhancement Additives
- Hiformer™ Liquid Additives for Polyolefins
- Cesa™ Non-PFAS Process Aid for Extrusion
- Cesa™ Additives for Polyolefin Films
- Cesa™ Clean Additives
- Cesa™ CTR Additives
- Cesa™ Dry Additives
- Cesa™ Mix Additives
- Cesa™ PlastOne™ Processing Enhancing Additive
- Cesa™ Process Additives
- Cesa™ Release Additives
- Cesa™ Slip Additives
- Cesa™ Stat Antistatic Additives
- Colorant Chromatics™ Evoluscend™ Non-PFAS High-Temperature Mold Release Additive
- ColorMatrix™ Eze™ Slip Agent for PET
- ColorMatrix™ SmartHeat™ RHC
- Hiformer™ NuAge™ Polypropylene Nucleating Agent
- Cesa™ Raise Heat Stability Modifier for APET Packaging
- Colorant Chromatics™ PVDF Processing Aids
- Reheat Additives for PET
- Repellant & Antimicrobial Additives
- Cesa™ Aversive Technology
- Cesa™ Fiber Antimosquito Additives
- Cesa™ WithStand™ Antimicrobial Additives
- Surface Modifier Additives
- Cesa™ Anti-Block Slip LS
- Cesa™ Anti-phenolic Yellowing Additives
- Cesa™ Impact Modifiers
- Cesa™ Anti-Block Additives
- Cesa™ Anti-Fog Additives
- Cesa™ Anti-Fog Plus Additives for Multilayer Films
- Cesa™ Clean Additives
- Cesa™ Dry Additives
- Cesa™ Grip Additives
- Cesa™ Low Retention Additives
- Cesa™ Scratch & Mar Resistance Additives
- Cesa™ Slip Additives
- Colorant Chromatics™ Evoluscend™ Non-PFAS High-Temperature Mold Release Additive
- ColorMatrix™ Eze™ Slip Agent for PET
- OnCap™ Anti-Fogging Additives
- UV and Light Blocking Additives
- Cesa™ Light Additives
- ColorMatrix™ Lactra™ Four, One, Zero
- ColorMatrix™ Lactra™ SX Light Blocking Additive for PET
- ColorMatrix™ Ultimate™ UV390 Light Barrier for PET
- ColorMatrix™ Ultimate™ UV390R Light Barrier for rPET
- ColorMatrix™ Lactra™ ESL
- Visual Enhancement Effects
- Cesa™ IR Additives
- Cesa™ Bright Optical Brighteners
- Cesa™ Mat Additives
- Cesa™ Scratch & Mar Resistance Additives
- ColorMatrix™ Optica™ Specialty Toners for PC
- ColorMatrix™ Optica™ Toners & Colors for Enhanced Recyclability
- Cesa™ Light Diffusion Masterbatch
- OnColor™ Edgeglo™ Colorants
- OnColor™ FX™ Special Effect Colorants
- OnColor™ Impress™ High Gloss Metallic Effect Colorants
- OnColor™ Lux Colorants
- Smartbatch™ Fabric FX
- Smartbatch™ FX for Paint Replacement
- Polymer Colorants
- Biopolymer Colorants and Additives
- Cesa™ Bio Additives
- Mevopur™ Healthcare Bio-based Polymer Solutions
- OnColor™ Bio Colorants
- OnColor™ Naturals Colorants
- Color & Additive Combination Masterbatches
- OnColor™ WPC Capstock Technology
- Smartbatch™ Combination Colorants & Additives
- Smartbatch™ Fabric FX
- Smartbatch™ FX for Paint Replacement
- Colorant Dispersions
- Colorants for High Consistency Silicone Rubber
- Colorants for Liquid Silicone Rubber
- Stan-Tone™ EPX Epoxy Dispersions
- Stan-Tone™ ET Polyether Dispersions
- Stan-Tone™ FSP Silicone Paste Dispersions
- Stan-Tone™ HC Plus Silicone Dispersions for Healthcare
- Stan-Tone™ HCC Vinyl Paste Dispersions
- Stan-Tone™ PEP Polyester Dispersions
- Stan-Tone™ RBX Rubber Dispersions
- Stan-Tone™ VC and VCP Vinyl Dispersions
- Stan-Tone™ WDN Water-Based Dispersions
- Colorants and Additives for Wire & Cable
- Cesa™ Aversive Technology
- Cesa™ Dry Silane Additives For Wire & Cable
- Cesa™ Flame Retardant Additives
- Cesa™ Laser Marking Additives
- Colorant Chromatics™ Dispersed Pigments for PTFE
- Colorant Chromatics™ ECTFE / ETFE Colorants
- Colorant Chromatics™ FEP Colorants
- Colorant Chromatics™ Inks
- Colorant Chromatics™ LND Coatings
- Colorant Chromatics™ Low Temperature Inks
- Colorant Chromatics™ Marking Inks
- Colorant Chromatics™ PEEK and PEI-Siloxane (SILTEM™ resin) Colorants & Pre-colored Solutions
- Colorant Chromatics™ PFA/MFA Colorants
- Colorant Chromatics™ PVdF Colorants
- Colorant Chromatics™ Reinforced Formulations
- OnColor™ Colorants for Wire & Cable
- Smartbatch™ Combination Colorants and Additives
- Fiber Colorants
- Fluoropolymer Color Concentrates
- Colorant Chromatics™ Dispersed Pigments for PTFE
- Colorant Chromatics™ ECTFE / ETFE Colorants
- Colorant Chromatics™ FEP Colorants
- Colorant Chromatics™ PFA/MFA Colorants
- Colorant Chromatics™ PVDF Colorants
- SiteCool™ Infrared Absorption Technologies
- Healthcare Colorants
- Colorant Chromatics™ Transcend™ Premier Healthcare Colorants
- Mevopur™ Healthcare Bio-based Polymer Solutions
- Mevopur™ Healthcare Colorants and Formulations
- Mevopur™ LQ Liquid Color & Additives for Healthcare
- Remafin™ EP White Colorants
- Stan-Tone™ HC Plus Silicone Dispersions for Healthcare
- High-Temperature Color Concentrates
- Colorant Chromatics™ Dispersed Pigments for PTFE
- Colorant Chromatics™ ECTFE / ETFE Colorants
- Colorant Chromatics™ FEP Colorants
- Colorant Chromatics™ Metallic Effect Pre-colored Sulfone Colorants
- Colorant Chromatics™ PEEK Colorants
- Colorant Chromatics™ PEEK and PEI-Siloxane (SILTEM™ resin) Colorants & Pre-colored Solutions
- Colorant Chromatics™ PFA/MFA Colorants
- Colorant Chromatics™ PVdF Colorants
- Colorant Chromatics™ Sulfone Colorants with Ultrason® High Performance Polymers
- Colorant Chromatics™ Transcend™ Biocompatible PEEK Pre-colored Compounds
- Colorant Chromatics™ PEI Color Colorants
- Colorant Chromatics™ PES/PSU/PPSU Colorants
- Colorant Chromatics™ Transcend™ Premier Healthcare Colorants
- Infrared Detection Colorants
- Liquid Color Concentrates and Dosing
- Color Management: ColorMatrix Select
- ColorMatrix™ Optica™ Specialty Toners for PC
- ColorMatrix™ Optica™ Toners For PET
- OnColor™ Impress™ High Gloss Metallic Effect Colorants
- Mesa™ Liquid Colorants
- Mevopur™ LQ Liquid Color & Additives for Healthcare
- Liquid Metering System: ColorMatrix™ FlexCart™
- Liquid Metering System: ColorMatrix™ FlexOne™
- Solid Color Masterbatches
- Mesa™ Solid and Dry Blend Colorants
- Mevopur™ Bio-based Polymer Solutions
- OnColor™ Bio Colorants
- OnColor™ Edgeglo™ Colorant
- OnColor™ for Wire & Cable
- OnColor™ FX™ Special Effect Colorants
- OnColor™ Naturals Colorants
- OnColor™ NIR Sortable Colorants
- OnColor™ REC Polymer Colorants
- OnColor™ SC Super Concentrate Technologies
- OnColor™ SenseAction™ Custom Colorants for Caps
- OnColor™ UL 94 Colorants
- Omnicolor™ Multipurpose Colorants
- Rejoin™ PCR Colorants
- Remafin™ Concentrates for Polyolefins
- Remafin™ EP White Colorants
- Renol™ Concentrates for Non-Olefins
- OnColor™ Lux Colorants
- Renol™ Concentrates for Non-Olefins
- Organoleptic Colorants & Additives
- Thermoplastic Elastomers
- Dynaflex™ Thermoplastic Elastomers
- Dynalloy™ Thermoplastic Elastomers
- GLS™ TPEs with Antimicrobial Technologies
- OnFlex™ Thermoplastic Elastomers
- reSound™ BIO Thermoplastic Elastomers
- reSound™ REC Recycled Content Thermoplastic Elastomers
- reSound™ Ultra-Low Carbon Footprint TPEs
- Stat-Tech™ TPE Static Dissipative & Electrically Conductive Thermoplastic Elastomers
- Versaflex™ HC Thermoplastic Elastomers
- Versaflex™ Low Adhesive Build-up TPE for Protective Film Tack Layer
- Versaflex™ Non-Blooming TPEs for Consumer Electronics
- Versaflex™ PF Tack Layer For Surface Protective Films
- Versaflex™ TF Adhesive TPEs for Textile Fabrics
- Versaflex™ Thermoplastic Elastomers
- Versalloy™ Thermoplastic Elastomers
- Versollan™ Thermoplastic Elastomers
- In-Vivo Formulations for Healthcare
- Vinyl Formulations
- Engineered Fiber Solutions
- Performance Fiber Conversion Calculator
- High Performance Synthetic Fibers
- Carbon Fiber
- Fiberglass
- Kevlar® Para-Aramid
- Nomex® Meta-Aramid
- Novoloid Phenolic Fiber
- PET Polyester Fiber
- Technora® Fiber
- Ultra-High Molecular Weight Polyethylene
- Vectran® Liquid Crystal Polymer
- Zylon® PBO Fiber
- Fiber-Line™ Performance Enhancing Processes
- Customized Braiding
- Fiber Twisting
- Performance Enhancing Coating
- Polymer Jacket Extrusion
- Precision Winding
- Pultrusion: Composite Fiber Rods
- Fiber-Line™ Engineered Fiber Products
- Belt & Hose Reinforcement Yarn
- Fiber Reinforced Polymer
- Industrial Fabric Yarn
- Ripcords for Fiber Optic Cable
- Strength Members
- Water Blocking & Absorbing Yarn
- Wire Harness Yarn
- Yarn for Compression Packing
- Kevlar® Distribution Program
- Protective Materials
- All Brands

Cesa™ Aversive Technology
Low-concern masterbatches that protect wire and cable from rats and termites
More
Cesa™ Withstand™ Antimicrobial Additives
Cesa™ WithStand™ Antimicrobial Additives give your plastic products an added layer of defense against microorganisms such as bacteria, mold, and fungi.
More
TPEs with Antimicrobial Technologies
Protect your finished part with GLS™ TPEs with imbedded additives
More